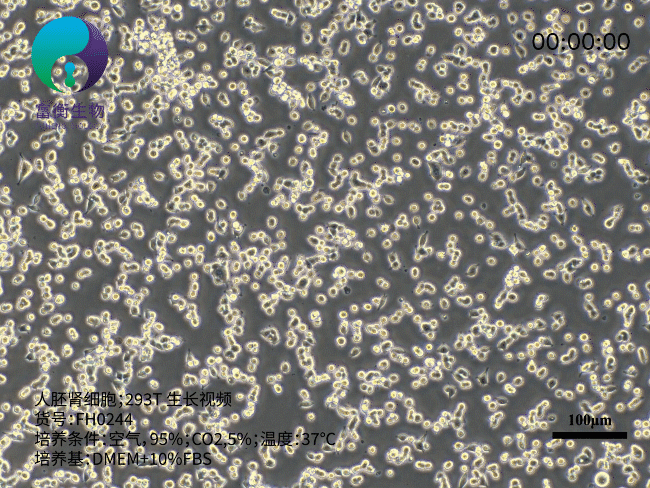
人胚肾细胞；293T.gif

5 年
手机商铺
入驻年限:5 年
刘胜富
上海 闵行区
抗体、ELISA 试剂盒、细胞库 / 细胞培养、论文服务、试剂、实验室仪器 / 设备、技术服务、耗材
代理商 经销商 生产厂商 科研机构
技术资料/正文
98 人阅读发布时间:2025-04-14 10:48
在生物研究领域,人胚肾细胞 293T 堪称耀眼的明星。它形态独特,呈现出扁平且不规则的模样,于培养皿底部贴壁生长。透过显微镜观察,这些细胞宛如一片片随意散落的微小纸片。其繁殖能力更是惊人,一旦处于适宜环境,短间内数量便会呈指数级攀升,仿佛掌握了神奇的 “分身术”,快速扩充着自己的 “家族” 规模 。
293T 细胞并非自然演化而来,它的问世凝聚着科研人员的智慧结晶。科研人员以人胚胎的肾脏细胞为起始材料,凭借精湛的专业技术,将猴病毒 40 的大 T 抗原基因无误地转入普通的人胚肾细胞 293 中,成功培育出 293T 细胞。这一成果为后续诸多科研突破筑牢了根基,开启了新的研究篇章。
培养 293T 细胞并非难事。准备好常规的细胞培养液,添加适量血清,血清就如同为细胞提供丰富营养的 “营养液”。将培养环境的温度稳定控制在 37℃上下,这个温度模拟了人体体温,是细胞*为适应的环境温度。同时,搭配 5% 的二氧化碳,以此维持培养液的酸碱平衡。当满足这些条件后,293T 细胞便能在培养环境中活力满满地生长、繁殖 。

在科研的广阔天地里,293T 细胞发挥着极为关键的作用。在基因功能研究中,科研人员将目标基因导入 293T 细胞内,通过细致观察细胞的种种变化,逐步揭开基因蕴含的奥秘。在病毒学研究进程中,它充当着病毒的 “宿主”,助力科学家深入洞悉病毒感染细胞的过程以及复制机制。在生物制药行业,293T 细胞更是不可或缺,它能够生产重组蛋白和病毒载体,为新型药物和疫苗的研发立下赫赫战功,在人类攻克疾病、守护健康的征程中,扮演着无可替代的重要角色 。